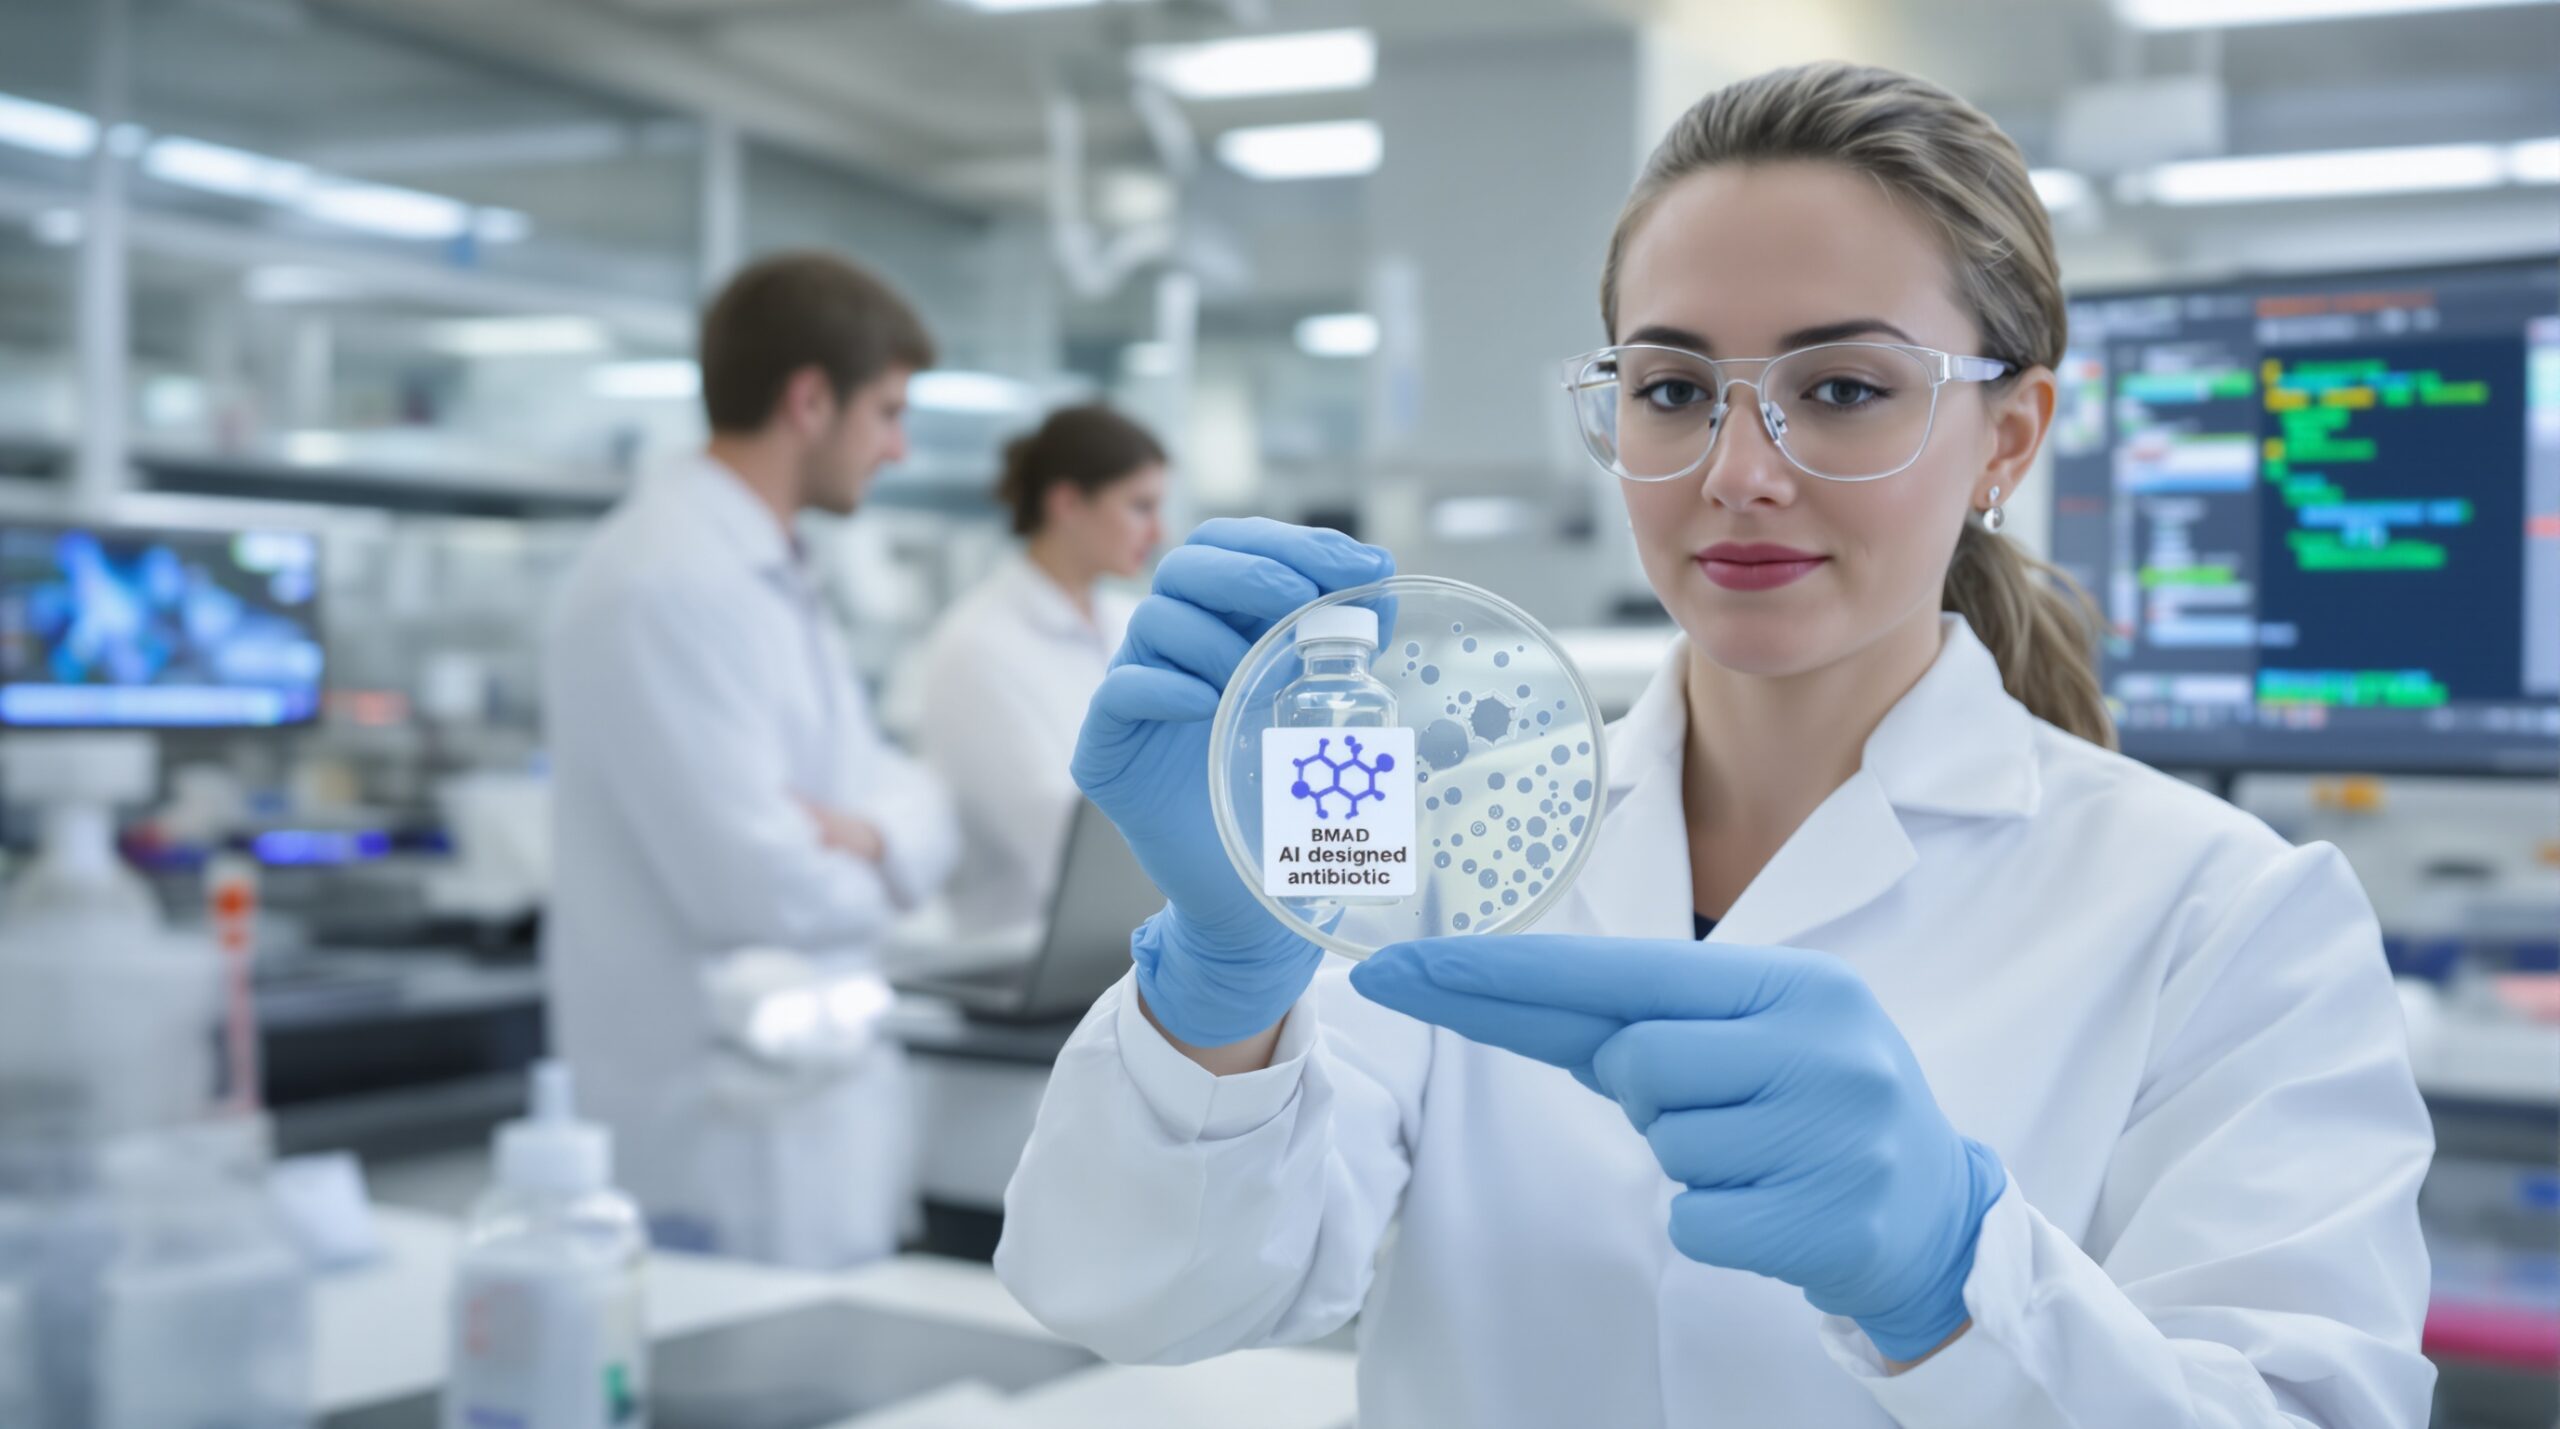

Drug-resistant infections threaten modern medicine by undermining routine care and lifesaving procedures. Hospitals now battle pathogens that withstand multiple drugs. Scientists are turning to artificial intelligence to discover new antibiotics faster. That pivot is already yielding encouraging leads and practical strategies.
Why New Antibiotics Are Urgently Needed
Bacteria evolve resistance through mutations, gene exchange, and intense drug pressure. Common infections are harder to treat and more expensive. Surgeries and chemotherapy carry greater risk when antibiotics fail. These trends demand new drug classes with novel mechanisms.
Traditional discovery has not kept pace with resistance. Screening campaigns consume years and significant capital. Many promising compounds fail due to toxicity or poor pharmacokinetics. Therefore, researchers seek tools that shorten timelines and boost success rates.
How AI Accelerates Antibiotic Discovery
AI models learn patterns linking molecular structures to antibacterial activity. They prioritize candidates from enormous libraries that humans cannot fully explore. Algorithms also flag compounds with favorable safety and absorption profiles. That guidance reduces laboratory workload and narrows experimental focus.
Teams use graph neural networks, transformers, and ensemble models for prediction. These architectures encode atoms, bonds, and physicochemical features. Models train on curated datasets of bacterial growth inhibition and toxicity. The resulting predictions guide synthesis and biological testing.
From Data to Actionable Molecules
High-quality data remains the foundation. Researchers assemble diverse chemical structures and validated activity measurements. They include negative results to reduce false positives. This strategy helps models distinguish general antibiotics from narrow-spectrum agents.
After training, models screen millions of molecules within hours. They rank hits by predicted potency and novelty. Chemists then evaluate synthetic accessibility and intellectual property landscape. The most promising molecules advance to wet-lab testing.
Early Breakthroughs Demonstrate Tangible Potential
One early example, halicin, emerged from AI-guided screening. It showed activity against multiple drug-resistant bacteria in laboratory studies. Researchers also observed efficacy in a mouse infection model. These results suggested a distinct mechanism and broad action.
Another program identified a compound that targets Acinetobacter baumannii. The candidate displayed narrow-spectrum activity in preclinical models. It spared helpful bacteria while suppressing a dangerous hospital pathogen. Researchers validated activity in a wound infection model.
Such findings inspired additional efforts. Teams now apply similar workflows to other high-priority pathogens. They also explore combinations that enhance activity or limit resistance. Momentum continues to grow across academia and industry.
Why Novel Mechanisms Matter
New mechanisms can outmaneuver existing resistance. Traditional targets like ribosomes and cell wall enzymes face widespread defenses. AI can prioritize scaffolds unlike known antibiotics. This novelty reduces cross-resistance and expands therapeutic options.
Some AI-selected molecules disrupt bacterial membrane potential. Others interfere with envelope assembly or nutrient pathways. These approaches exploit vulnerabilities specific to pathogens. Importantly, they may preserve beneficial microbiota when designed narrowly.
The Rise of Generative Design
Beyond screening, generative models propose new molecules de novo. Algorithms optimize potency, selectivity, and predicted safety simultaneously. Researchers constrain designs to maintain synthetic feasibility. This workflow can iterate rapidly as data improves.
Reinforcement learning and diffusion models guide exploration toward promising chemistries. Multi-objective optimization balances antibacterial activity with drug-like properties. Teams further filter designs against human toxicity risks. These safeguards improve the quality of proposed candidates.
Validating Hits with Robust Experiments
Computational predictions require careful laboratory validation. Scientists test hits against clinical isolates and biofilms. They measure minimal inhibitory concentrations across diverse conditions. Pharmacologists assess absorption, distribution, metabolism, and excretion in animal models.
Mechanistic studies clarify how compounds kill bacteria. Researchers use genetics, proteomics, and microscopy to pinpoint targets. They monitor resistance emergence during serial passaging experiments. These steps shape dosing strategies and stewardship plans.
Advantages Over Traditional Approaches
AI narrows candidate lists dramatically. That efficiency reduces costs while raising the chance of success. Models also uncover nonintuitive relationships missed by human intuition. These insights can reveal fresh chemical space and targets.
Another advantage involves tailored spectrum design. Narrow-spectrum antibiotics reduce collateral damage to the microbiome. They potentially decrease selection pressure for resistance in bystander species. AI helps balance spectrum with clinical coverage needs.
Balancing Promise with Practical Challenges
Data quality remains a limiting factor. Inconsistent assays can mislead models and waste resources. Collaborative standards and open datasets can mitigate this issue. Strong validation pipelines also prevent overconfidence in predictions.
Model interpretability poses another challenge. Clinicians and regulators value explanations of predicted activity. Emerging methods highlight structural features driving outputs. These tools support better decision-making and safer designs.
Safety, Toxicity, and Off-Target Risks
Any antibiotic must spare human cells at therapeutic doses. AI models estimate cardiotoxicity, genotoxicity, and liver risks. However, in vivo testing remains essential and irreplaceable. Integrated workflows combine prediction with rigorous safety studies.
Researchers also evaluate microbiome impacts. Narrow-spectrum candidates may lessen dysbiosis after treatment. That feature could improve recovery and limit opportunistic infections. Careful monitoring will guide safe clinical use.
Manufacturing and Pharmacokinetic Considerations
Promising molecules must be manufacturable at scale. Chemists refine routes to reduce steps and environmental impact. Formulation scientists enhance solubility and stability. These efforts enable reliable dosing and global distribution.
Pharmacokinetics determine whether a drug reaches infected tissues. AI can predict properties that support oral or intravenous dosing. Animal studies confirm exposure and tissue penetration. Those data inform clinical trial designs and endpoints.
Clinical Trials and Regulatory Pathways
New antibiotics progress through phase-based trials to demonstrate safety and efficacy. Regulators may provide streamlined pathways for serious infections. Sponsors must still deliver robust evidence and post-market surveillance plans. Thoughtful stewardship remains part of the approval discussion.
AI can enrich trials by selecting patients most likely to benefit. It can also detect early safety signals. These contributions accelerate learning during development. Continuous feedback then improves subsequent molecules.
Stewardship, Access, and Sustainable Incentives
Successful antibiotics require responsible use to preserve effectiveness. Hospitals implement guidelines and rapid diagnostics to guide therapy. Payers and policymakers explore subscription models for access. These policies support innovation while limiting inappropriate use.
Global access is equally vital. Drug-resistant infections burden low-resource settings heavily. Equitable licensing and affordable manufacturing can expand reach. Partnerships can align incentives across public and private sectors.
What Comes Next for AI Antibiotics
The field now scales toward larger, more diverse datasets. Better bacterial phenotyping and standardized assays will strengthen models. Integration with structural biology can reveal targetable pockets. This convergence should refine design and reduce attrition.
Combination therapies also merit attention. AI can predict synergistic pairs that suppress resistance. Such strategies may restore activity of older drugs. They also extend the lifespan of new agents.
A Measured Optimism
AI will not replace biology, but it will augment it powerfully. Early successes validate the approach and motivate investment. Challenges remain in data, interpretability, and clinical translation. Yet the trajectory points toward meaningful clinical impact.
Researchers, clinicians, and regulators must collaborate closely. With careful validation and stewardship, AI-designed antibiotics could transform infectious disease care. Patients stand to benefit from safer, more precise therapies. Progress today sets the stage for broader breakthroughs tomorrow.